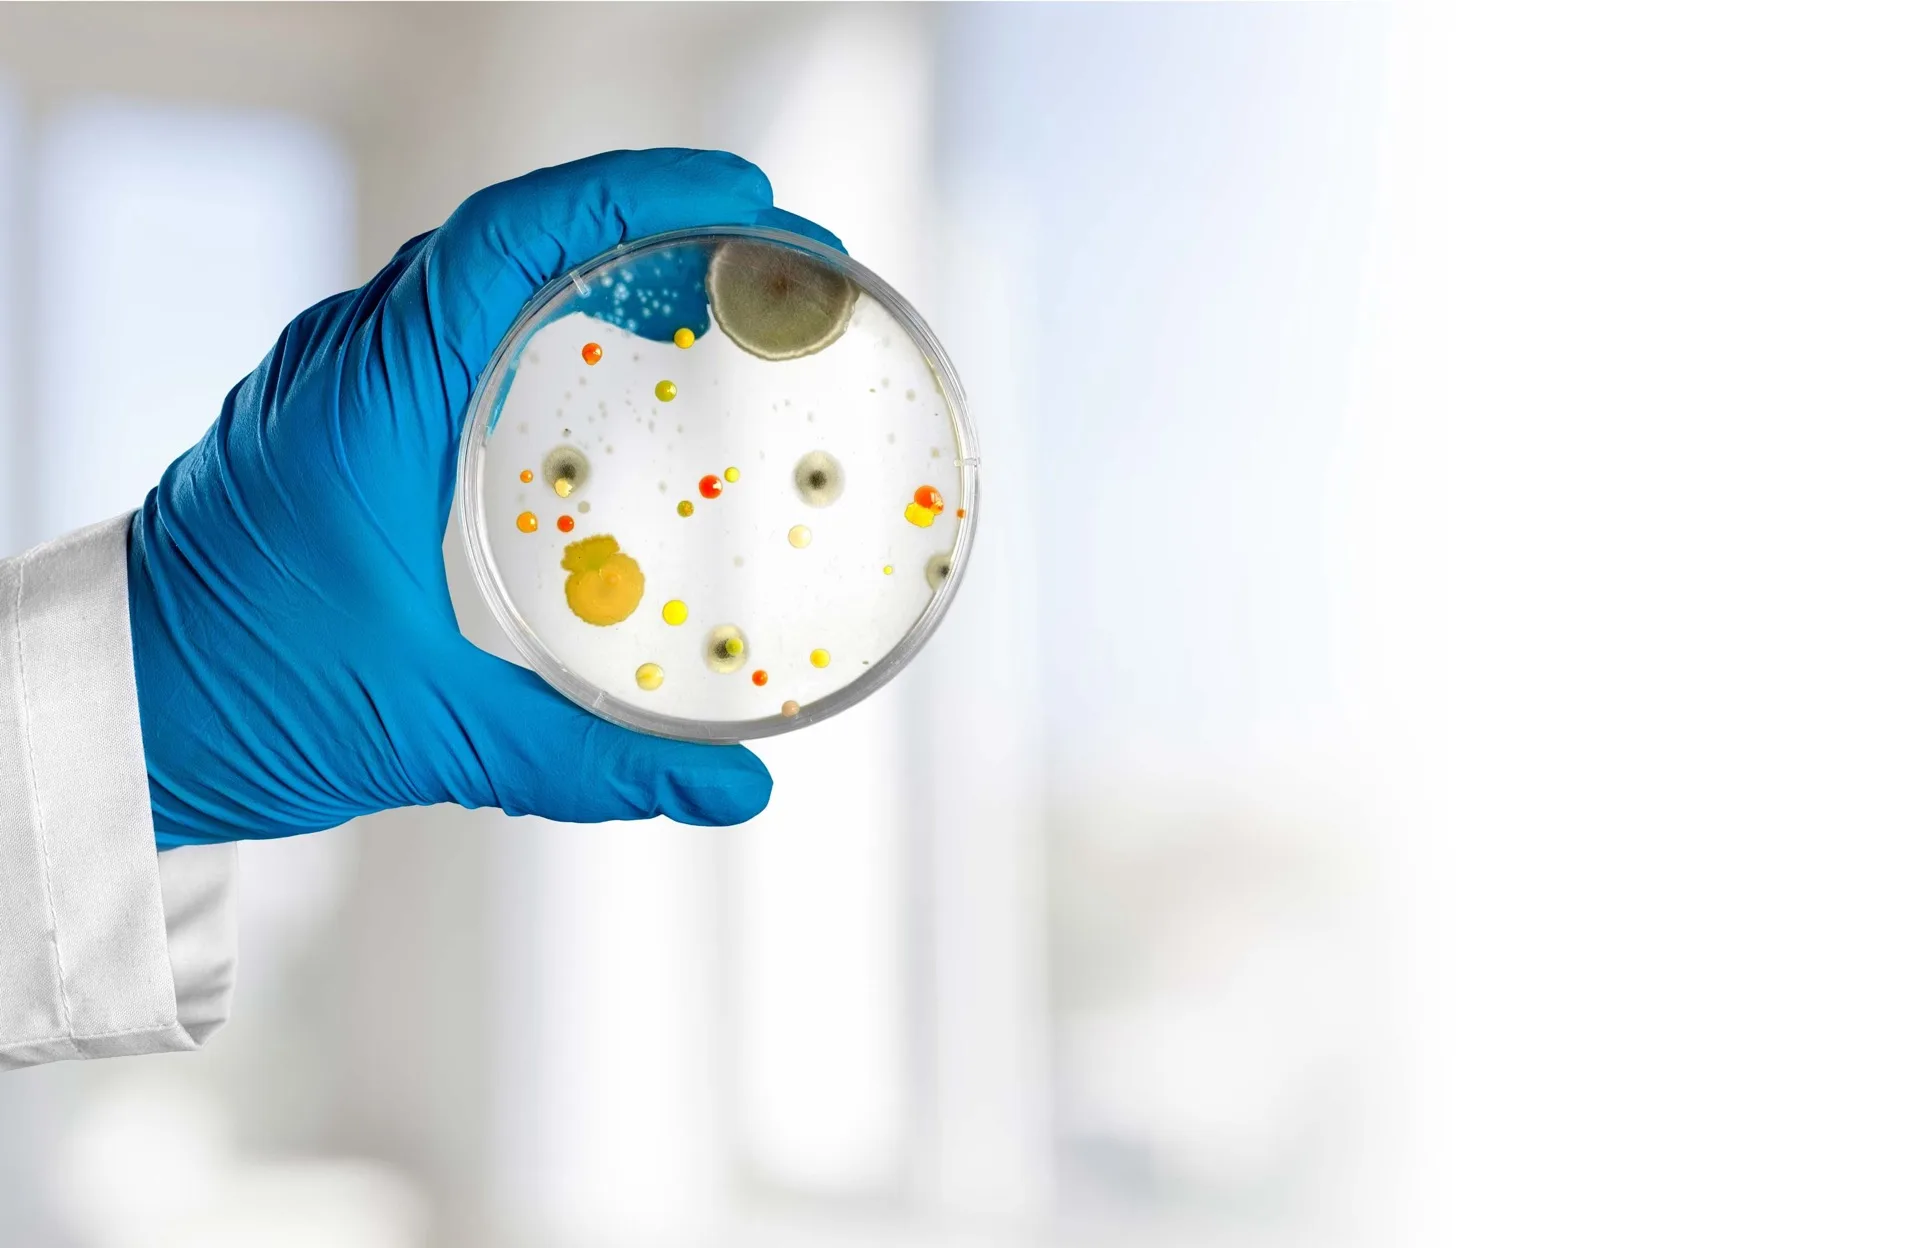

Everything You Could Ever Want in a Lab Partner
Fast, expert, and fully independent laboratory testing built for IAQ professionals, mold inspectors, and property managers. From spore counts to asbestos, lead to bacteria—we deliver accurate, defensible results that keep your projects on track and your clients breathing easy.
Your Lab Wish List — Fulfilled
We built our lab around the things inspectors and property managers actually need: speed, accuracy, accessibility, and real human support.
Profit-Driving IAQ Testing
Indoor air quality goes far beyond mold. By offering a broader panel of tests—asbestos, allergens, bacteria, lead, VOCs, mycotoxins—you expand the scope of every project and increase your revenue per engagement. We make it easy to add these services to your toolkit with straightforward pricing and fast results.
Real Scientists, Real Answers
When you have questions about results, sampling methods, or report interpretation, you talk directly to the scientists who analyzed your samples. No call centers, no ticket queues. We respond quickly across phone, email, or text—whatever keeps your projects moving forward without delay.
Same-Day Turnaround Available
Tight deadlines are the norm in the inspection and property management world. Mold analysis results can be delivered in as few as 3 hours for rush cases. Standard turnaround is 48–72 hours, and we consistently meet those timelines so you can keep your commitments to your clients.
Free Shipping & Local Drop-Off
Getting your samples to us should be the easiest part of your job. We provide prepaid shipping labels for nationwide service at no additional cost. Based in Florida, we also offer local drop-off options for inspectors in the area—reducing turnaround time even further.
Grow Your Business
Boost Your Profitability with Broader Testing
Most inspectors leave money on the table by limiting their services to a standard mold test. The reality is that your clients often have broader concerns—and broader budgets—than a single spore trap can address.
By expanding your testing panel to include mycotoxins, VOCs, bacteria identification, allergens, and building material hazards like asbestos and lead, you transform a routine inspection into a comprehensive indoor air quality assessment. The result? Higher value per project, stronger client trust, and a reputation as the go-to expert in your market.
We make it easy. Our quick-reference guide helps you identify common conditions that warrant additional testing so you can recommend the right services at the right time.
Available Add-On Tests
Mycotoxin Screening
Identify toxic mold byproducts beyond spore counts
VOC & Formaldehyde Testing
Pinpoint chemical off-gassing from building materials
Bacteria Identification
Go beyond total counts to identify specific species
Allergen Panel
Dust mites, pet dander, cockroach, and pollen antigens
Asbestos & Lead Analysis
Essential for pre-renovation and pre-1978 properties
Water Quality Testing
E. coli, coliform, and potable water screening
Have Questions? Talk to a Scientist.
Whether you need help choosing the right test, interpreting results, or understanding sampling methods—our lab team is a phone call away. No automated menus, no waiting on hold. Just real scientists who understand your work.
Hold Your Lab Partner to a Higher Standard
Not all labs are created equal. Here's what sets Integrity Labs apart from the rest—and why it matters for your business.
Truly Independent Laboratory
The indoor air quality industry is crowded with labs that also sell remediation services, creating an inherent conflict of interest. As an independent, third-party laboratory, we have no ties to remediation companies and no financial incentive to skew results. Our only interest is giving you accurate, unbiased data that protects both your clients and your professional reputation.
Customizable, Client-Ready Reports
Your lab reports are a reflection of your business. We offer customizable report templates so your deliverables look polished, professional, and consistent with your brand. Every IAQ report includes clear, color-coded scoring—green, orange, and red indicators—so even non-technical stakeholders can quickly understand air quality conditions.
Deep Industry Expertise
Our laboratory is staffed by trained scientists with advanced degrees and specialized training in mycology and environmental microbiology. We maintain ISO 17025 accreditation for mold analysis and participate in recurring proficiency testing programs to ensure our methods consistently meet the highest analytical standards.
Defensible, Court-Ready Results
Whether your report is going to a homeowner, a property manager, an insurance adjuster, or a courtroom, the data needs to hold up under scrutiny. Every sample we process follows documented chain-of-custody protocols, rigorous quality controls, and accredited analytical methods that produce results you can stand behind with confidence.
Standards and accreditations that back every result we deliver.
Testing Quick-Reference Guide
Not sure which test to recommend? Use this guide to match common field conditions to the right analysis, sampling material, and expected turnaround.
| Example Problem | Potential Analysis | Sampling Material | Report Format | Turnaround |
|---|---|---|---|---|
| You suspect mold growth somewhere in the home | Spore Count & Identification | Air Cassette | Spores/m³ | 3–8 Hours |
| You see what appears to be mold on an uneven surface | Spore Count & Identification | Swab | Rare, Low, Medium, High or Spores/cm² | 3–8 Hours |
| You see what appears to be mold on a flat surface | Spore Count & Identification | Tape Lift | Rare, Low, Medium, High or Spores/cm² | 3–8 Hours |
| Client reports feeling sick, but you’re unsure if mold is the cause | Particle Count & Identification | Air Cassette | Particles/m³ | 3–8 Hours |
| A house fire has occurred and soot contamination is a concern | Soot Analysis | Alcohol Swab | Present / Absent | 3–8 Hours |
| You suspect asbestos in building materials | Asbestos (PLM) | Bulk Sample | Absent, >1%, >3%, >10%, >20%, >50% | 3–8 Hours |
| You encounter a home built before 1978 | Lead Paint Analysis | Paint Chip (1″ × 1″) | Present / Absent | 3–8 Hours |
| You suspect biological growth that isn’t fungal or mold | Total Bacteria Count | Swab | CFU/swab | 24 Hours |
| You suspect biological growth and need species identification | Bacteria Count & Identification | Swab | CFU/swab + Species ID | 48 Hours |
| Water testing is needed to verify potable water safety | E. coli & Coliform | Water Sampling Bottle | Present / Absent | 24 Hours |
| A surface may have come in contact with sewage | E. coli & Coliform | Swab | Present / Absent | 24 Hours |
You suspect mold growth somewhere in the home
- Analysis
- Spore Count & Identification
- Material
- Air Cassette
- Report
- Spores/m³
- Turnaround
- 3–8 Hours
You see what appears to be mold on an uneven surface
- Analysis
- Spore Count & Identification
- Material
- Swab
- Report
- Rare, Low, Medium, High or Spores/cm²
- Turnaround
- 3–8 Hours
You see what appears to be mold on a flat surface
- Analysis
- Spore Count & Identification
- Material
- Tape Lift
- Report
- Rare, Low, Medium, High or Spores/cm²
- Turnaround
- 3–8 Hours
Client reports feeling sick, but you’re unsure if mold is the cause
- Analysis
- Particle Count & Identification
- Material
- Air Cassette
- Report
- Particles/m³
- Turnaround
- 3–8 Hours
A house fire has occurred and soot contamination is a concern
- Analysis
- Soot Analysis
- Material
- Alcohol Swab
- Report
- Present / Absent
- Turnaround
- 3–8 Hours
You suspect asbestos in building materials
- Analysis
- Asbestos (PLM)
- Material
- Bulk Sample
- Report
- Absent, >1%, >3%, >10%, >20%, >50%
- Turnaround
- 3–8 Hours
You encounter a home built before 1978
- Analysis
- Lead Paint Analysis
- Material
- Paint Chip (1″ × 1″)
- Report
- Present / Absent
- Turnaround
- 3–8 Hours
You suspect biological growth that isn’t fungal or mold
- Analysis
- Total Bacteria Count
- Material
- Swab
- Report
- CFU/swab
- Turnaround
- 24 Hours
You suspect biological growth and need species identification
- Analysis
- Bacteria Count & Identification
- Material
- Swab
- Report
- CFU/swab + Species ID
- Turnaround
- 48 Hours
Water testing is needed to verify potable water safety
- Analysis
- E. coli & Coliform
- Material
- Water Sampling Bottle
- Report
- Present / Absent
- Turnaround
- 24 Hours
A surface may have come in contact with sewage
- Analysis
- E. coli & Coliform
- Material
- Swab
- Report
- Present / Absent
- Turnaround
- 24 Hours
Ready to Partner with a Lab That Gets It?
ISO 17025 accredited. Same-day turnaround available. Free shipping nationwide. Submit your first samples today and see the difference.